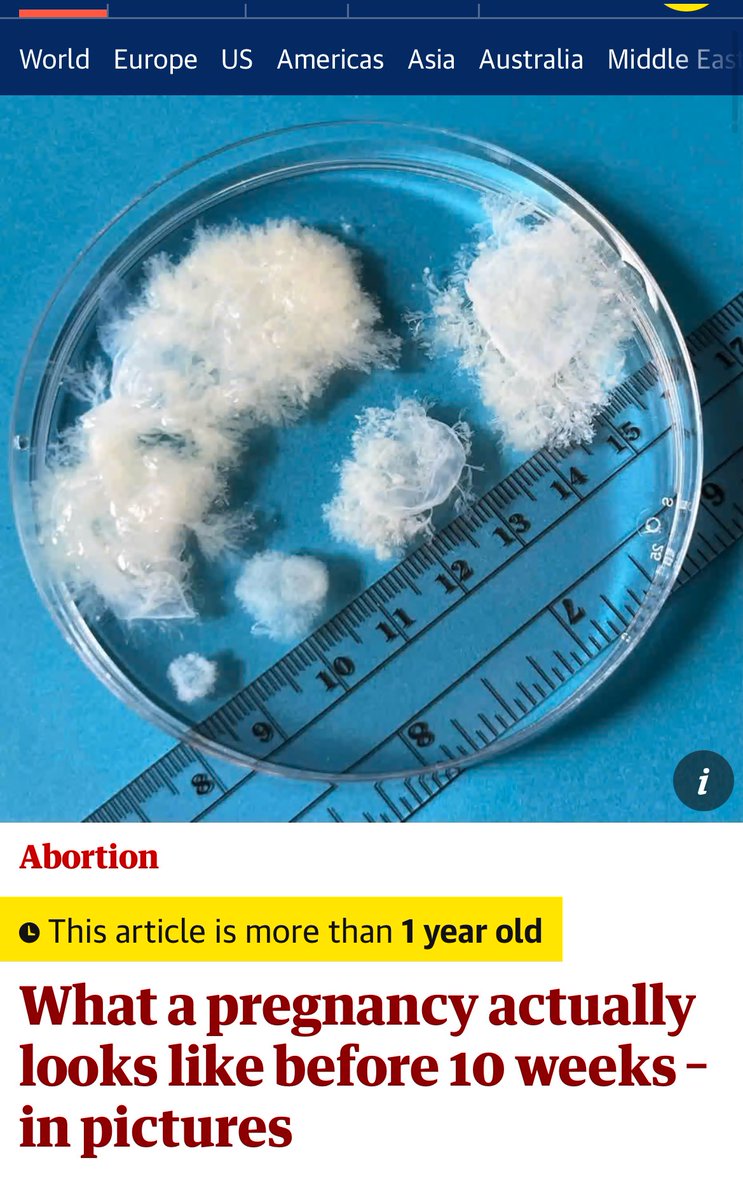
9 de cada 10 abortos se practican en el primer trimestre y lucen así:

Albóndiga🌾🌵
@arubcaz
Nolite te Bastardes Carborundorum -
GS Impeesa 379 - Grado de Historia en la UVa :))
@Daroba5 la candado
ID: 907916230090248192
13-09-2017 10:37:52
9,9K Tweet
253 Takipçi
646 Takip Edilen












La Asociación de Maltratadores de Viejas está ayudando a los necesitados 🤩 Menos mal que el Grupo Nacional Pateador de Gatos echa una mano en estos momentos de necesidad 🥰 Cómo ponerle mala cara al Núcleo de Apuñaladores de Bebés si están arrimando el hombro como el resto ☺️